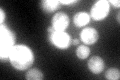
YER003C
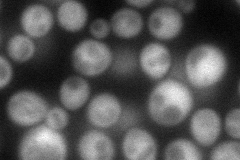
YER003C
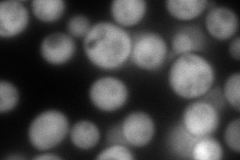
YER003C
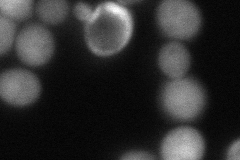
YER003C
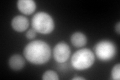
YER003C
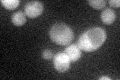
YER003C
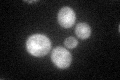
YER003C

View description
Mannose-6-phosphate isomerase, catalyzes the interconversion of fructose-6-P and mannose-6-P; required for early steps in protein mannosylation
Localization:
Intensity:
Fold change:
Significance:
-
C’ GFP library in SD
cytosol82.47 -
N' NOP1pr-GFP in SD
cytosol104.301 -
N' TEF2pr-mCherry in SD
cytosol215.576 -
N' NATIVEpr-GFP in SD

cytosol70.1357 -
N' TEF2pr-VC and Cyto-VN in SD
cytosol88.386 -
C’ GFP library in SD+DTT
cytosol212.612.57Yes -
C’ GFP library in SD+H2O2
cytosol94.651.14No -
C’ GFP library in Starvation Media
cytosol73.630.89No -
C’ GFP library on the background of Pup2-DaMP

cytosol -
C’ GFP library on the background of CCT mutant

cytosol75.84560.91953No
